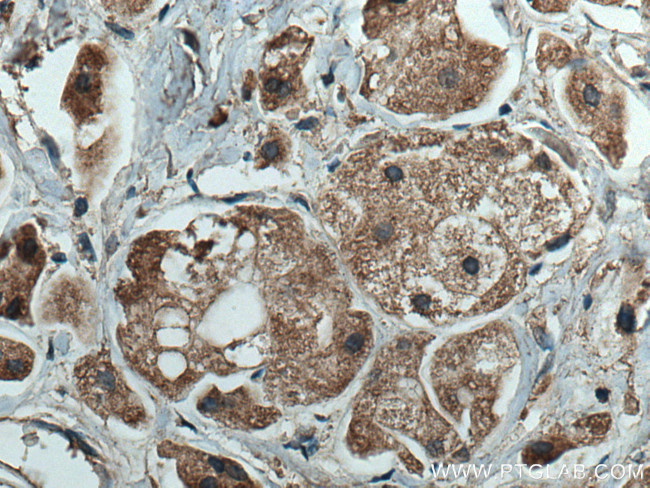
ROR1 Antibody in Immunohistochemistry (Paraffin) (IHC (P))

Search
Proteintech
ROR1 Monoclonal Antibody (1F5D8)
{{$productOrderCtrl.translations['antibody.pdp.commerceCard.promotion.promotions']}}
{{$productOrderCtrl.translations['antibody.pdp.commerceCard.promotion.viewpromo']}}
{{$productOrderCtrl.translations['antibody.pdp.commerceCard.promotion.promocode']}}: {{promo.promoCode}} {{promo.promoTitle}} {{promo.promoDescription}}. {{$productOrderCtrl.translations['antibody.pdp.commerceCard.promotion.learnmore']}}
产品信息
66923-1-IG
种属反应
宿主/亚型
分类
类型
克隆号
抗原
偶联物
形式
浓度
规格
纯化类型
保存液
内含物
保存条件
运输条件
产品详细信息
Aliquoting is unnecessary for -20°C storage.
靶标信息
Receptor-tyrosine-kinase-like orphan receptor 1 (ROR1) is a tumor-associated, surface protein predominantly expressed during embryogenesis, where it is involved in organ morphogenesis, nervous system development, and neural progenitor cell maintenance and survival. Virtually absent from normal pediatric and adult tissues, with the exception of low-level expression in a subset of immature b cell precursors known as hematogones and adipocytes, ROR1 is notably overexpressed, and considered a survival factor, in a number of B lymphoid and epithelial malignancies: including chronic lymphocytic leukemia (CLL), mantle cell lymphoma (MCL), acute lymphoblastic leukemia (ALL), marginal zone lymphoma, lung adenocarcinoma. First identified during PCR-based cloning of a human neuroblastoma cell line in search of tyrosine kinases similar to tropomyosin-receptor-kinase (Trk) neurotropic receptors, ROR1, along with the related receptor tyrosine kinase (RTK) ROR2, was catalogued as an "orphan" receptor due to the fact its related ligand remained elusive. Wnt-5a has since been suggested as a candidate ligand for ROR1, and ROR1 has been implicated to function as a pseudokinase, promoting proliferation and resistance to apoptosis in cancer cells through interaction with Wnt-5a, and TCL1-co-activation of AKT. ROR1 is expressed as a glycoprotein containing extracellular immunoglobulin (Ig)-like, Frizzled, and Kringle domains, as well as an intracellular region containing a tyrosine kinase domain.
仅用于科研。不用于诊断过程。未经明确授权不得转售。
生物信息学
蛋白别名: Inactive tyrosine-protein kinase transmembrane receptor ROR1; MGC99659; Neurotrophic tyrosine kinase, receptor-related 1; T-ROR1
基因别名: dJ537F10.1; NTRKR1; ROR1
UniProt ID: (Human) Q01973
Entrez Gene ID: (Human) 4919